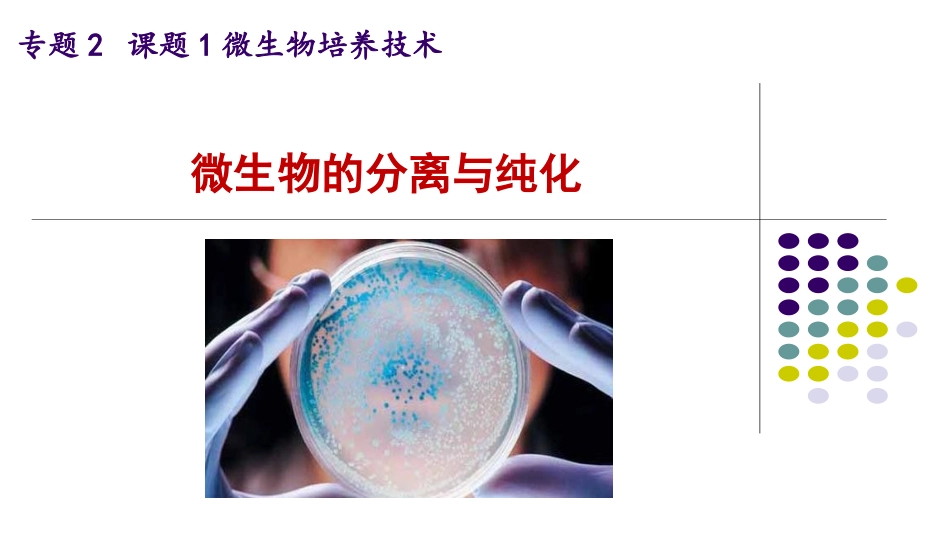

微生物的分离纯化高中生物高二选修一《生物技术实践》人教版专题2课题1微生物培养技术微生物的分离与纯化实验目的:1、了解微生物分离纯化的原理2、体验分离纯化微生物的方法和无菌操作技术3、了解鉴别微生物的方法实验材料、器具:大肠杆菌菌液、自带材料、无菌水、牛肉膏蛋白胨培养基、接种环、涂布器、取样器、酒精灯、酒精棉球(95%)、试管等(一)制备牛肉膏蛋白胨固体培养基实验过程:(二)分离纯化微生物(接种)(一)制备牛肉膏蛋白胨固体培养基实验过程:计算称量溶化灭菌倒平板倒平板技术3
锥形瓶瓶口通过火焰2
在酒精灯火焰旁操作4
培养皿打开一条缝隙,倒入培养基5
待平板冷却凝固后倒置注意事项1
操作前用酒精棉球擦拭双手防止杂菌污染实验流程1324特别提醒:无菌操作用火安全1、平板划线法:2、稀释涂布平板法:(二)分离纯化微生物(接种)2173645问题总结实验操作问题探究稀释涂布平板法:1
如何将菌液进行稀释
如何确定稀释倍数
6支试管,分别加入9ml无菌水1ml1011ml1021ml1031ml1041ml1051ml106a
梯度稀释菌液实验操作6支试管,分别加入9ml无菌水1ml1011ml1021ml1031ml1041ml1051ml106a
梯度稀释菌液b
涂布平板实验操作滴灼冷涂问题总结特别提醒:接种完毕,在培养皿上贴上标签,注明时间、姓名、班级、菌种种类、稀释倍数,将培养皿倒置将接种后的培养基放入37℃恒温箱中培养,同时放入一个未接种的培养基进行培养培养拓展:请利用本节课的技术探究你感兴趣的问题小结:微生物的分离纯化(一)制备牛肉膏蛋白胨固体培养基(二)微生物的分离与纯化1、平板划线法2、稀释涂布平板法计算称量溶化灭菌倒平板